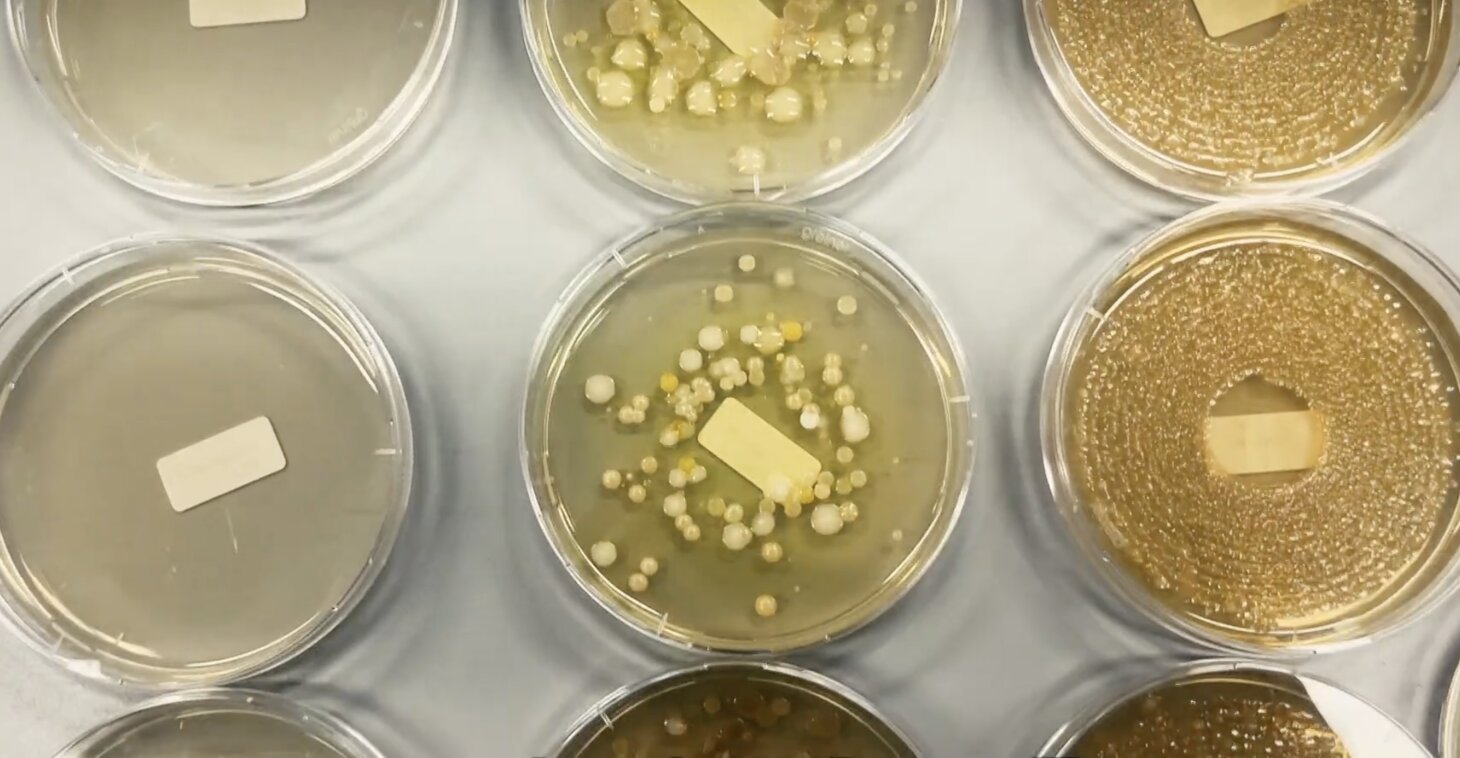
agar plates

LMM contributes to consumer test on dishwashing hygiene
The research group of Prof. Sandra Van Puyvelde recently collaborated with the Flemish consumer television programme WINWIN to investigate a simple yet highly relevant question: Which everyday dishwashing tool is the most hygienic? The segment, aired on 27 January, featured experiments conducted in our lab as part of the programme’s Brokkentest, where host Jacotte Brokken compared several commonly used cleaning tools.
Under the supervision of Prof. Sandra Van Puyvelde, our research group analysed four different dishwashing implements:
- a standard sponge
- an antibacterial sponge
- a Scrub Daddy
- a dishwashing brush
Each item was tested at three time points: day 0 (unused), day 1, and day 7. Bacterial samples were grown on agar plates to determine bacterial loads, allowing us to compare levels of bacterial contamination across all tools. In parallel, full-length 16S sequencing was performed on the samples to determine which types of bacteria were present and whether any potentially harmful organisms could be detected.
Clear results: the brush outperforms all sponges
Our findings revealed a consistent pattern: the dishwashing brush contained the lowest number of bacteria after both one and seven days of use. Among the sponges, there were no significant differences in overall bacterial load. However, the Scrub Daddy sponge can be cleaned in the dishwasher, leading to a drop in its bacterial levels.
No harmful bacteria detected
The sequencing results provided reassuring news. All detected bacteria were common environmental organisms that pose no health risk under normal conditions, and no pathogenic species were found in any of the samples.
Why this matters
This work illustrates how microbiological research can directly support public wellbeing. By investigating everyday household items, we help inform consumers about hygiene and safety in daily life. The collaboration underscores our commitment to conducting research with tangible societal benefit, bridging the gap between microbiology and practical concerns in everyday life.
The full test can be viewed on VRT MAX – in Dutch (Brokkentest from 1'50" to 7'16").